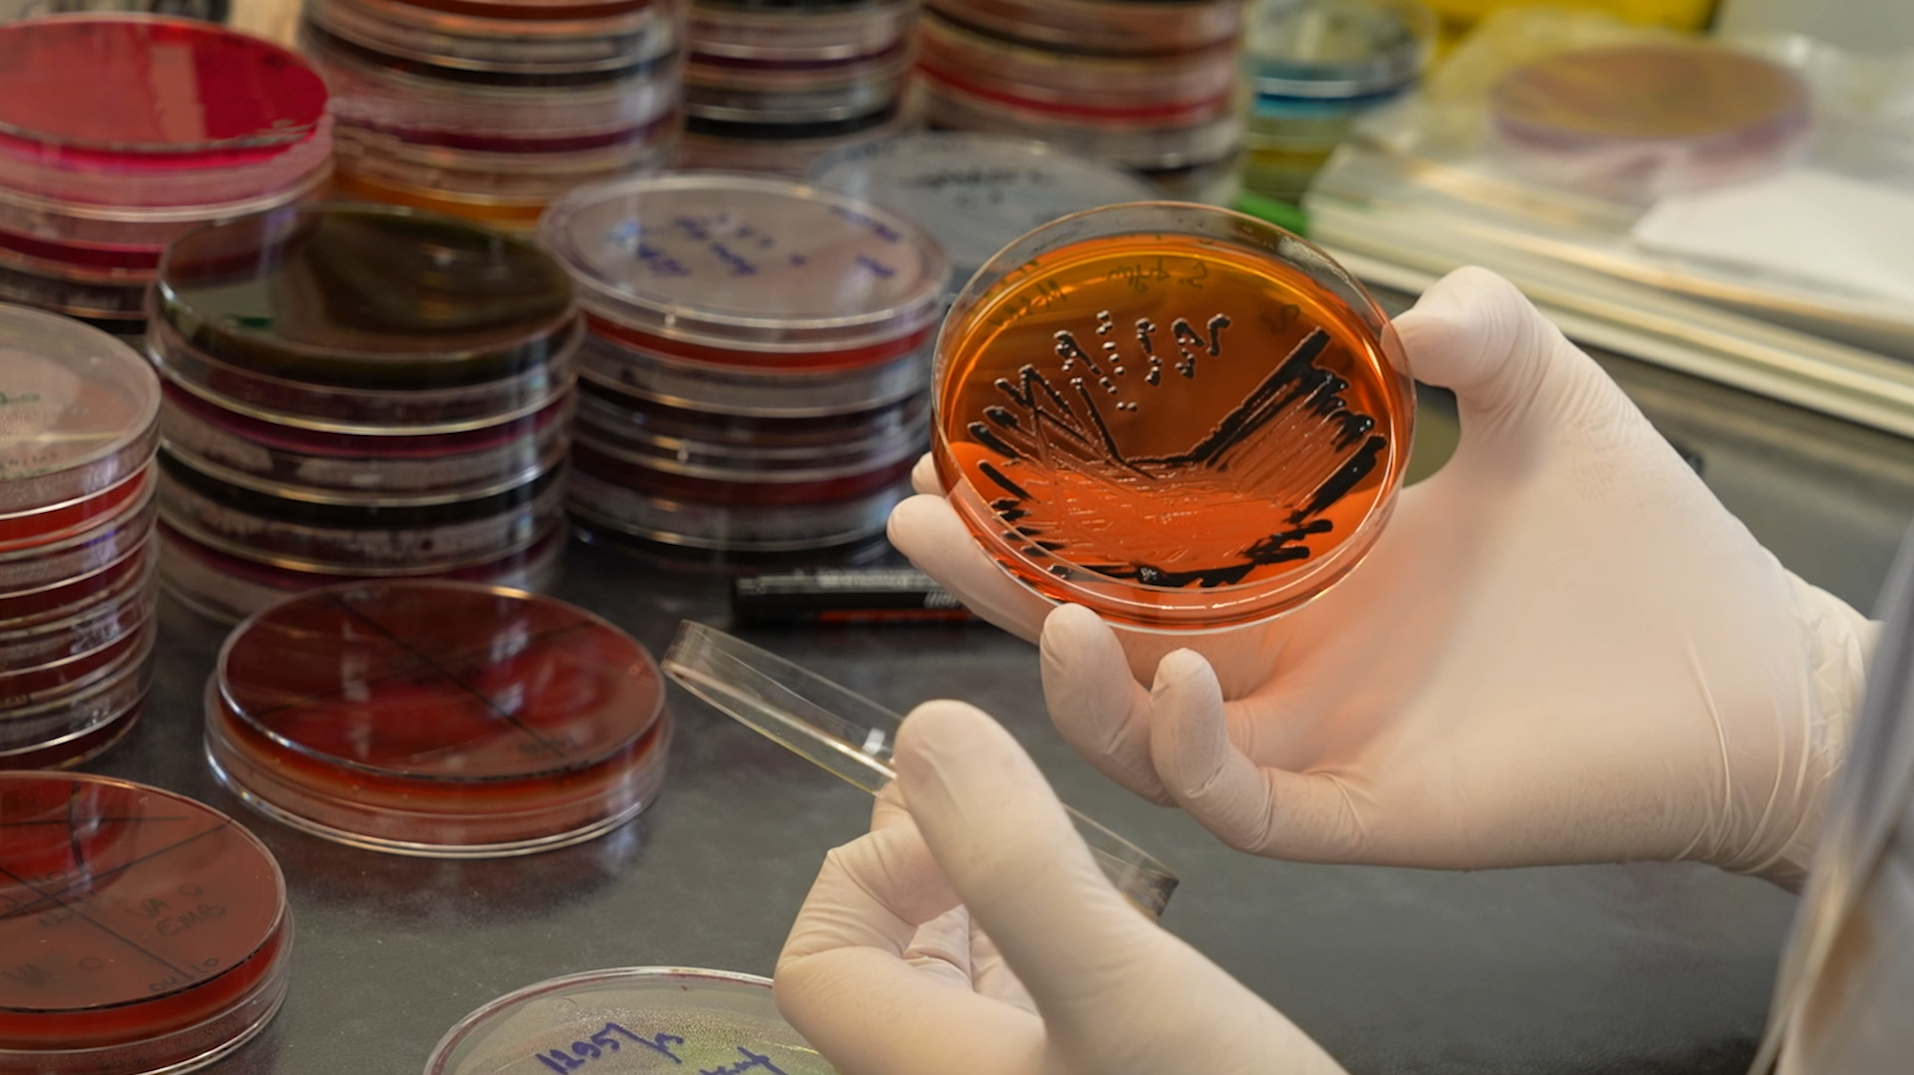

672

- Detailid
- Esmane info
- Ettevõte
Ootused kandidaadile
- sul on esimese astme kõrgharidus (soovitavalt loodusteadused);
- sul on huvi mikrobioloogia vastu;
valdad heal tasemel eesti keelt;
- oled isikuomadustelt hea suhtleja, oma ülesannetes kohusetundlik, järjepidev, süsteemne ja Sul on hea õppimisvõime;
- oskad töötada meeskonnas, olles toetav ja mõistev kolleeg.
Kindlaks eeliseks on varasemad laboritöö kogemused. Töö sobib neile, kes ei karda kokkupuudet bioloogilise ohuteguriga.
Tööülesannete kirjeldus
Peamine ülesanne on mikrobioloogliste ja parasitoloogiliste analüüside teostamine.
Omalt poolt pakume
- toetavat ja ühtehoidvat kollektiivi;
- huvitavat ja mitmekesist tööd kaasaegses laboris;
- enesetäiendamise võimalusi;
- töökohta Kuressaare vanalinnas;
- laboripoolseid soodustusi (sportimis-ja tervisesoodustused, 7- päevane lisapuhkus, 5 energiapäeva aastas).
Selle ametikoha keskmise palga info leiad aadressilt palgad.ee.
Asukoht
- Kuressaare, Saaremaa, Eesti
Kohtu 16
Tööaeg
- Täistööaeg
Oskused
Keeled
- Eesti
Kontaktisik
Kaire Linamägi
Kaire Linamägi
Riigi Laboriuuringute ja Riskihindamise Keskus (LABRIS) on Regionaal- ja Põllumajandusministeeriumi valitsemisalas tegutsev ministeeriumi hallatav riigiasutus, kuhu on koondunud toidu- ja söödaohutuse ning loomatervise valdkonna laboriteenused, riskihinnangute andmine ning riikliku referentlaboratooriumi volituste täitmine.
Sarnased töökuulutused:
Abiõpetaja
Pitsameister-klienditeenindaja
Kontoriassistent